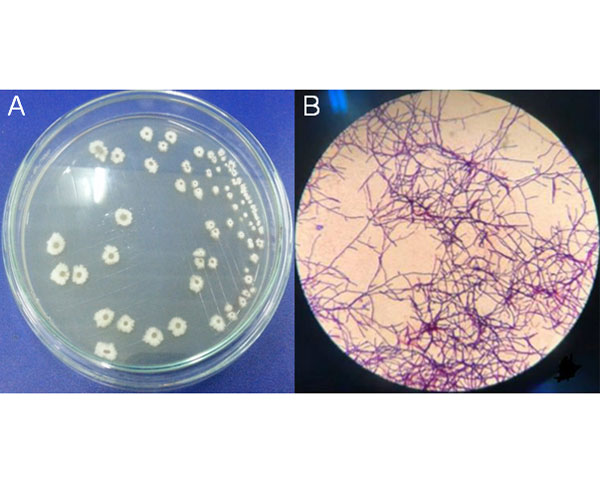

Songklanakarin Journal of Science and Technology (SJST)
Volume 45 No.1 (January - February 2023)
pp. 1 - 164
Jasmine essential oil promotes delta-beta power activities in the dorsal hippocampus under slow wave sleep promotion
Dania Cheaha, Nurulhuda Basor, Nusaib Sa-i, Ekkasit Kumarnsit, Anthony Chaikul and Nifareeda Samerphob

The effect of edible film on properties and specific sensory attributes of a gac (Momordica cochinchinensis Spreng) aril product
Somporn Tanskul, Nutjakan Rattanacharun and Singhaneit Phanaphitakkul

Density and management of estuarine crocodile in Samarahan river basin, Sarawak, Malaysian Borneo
Ruhana Hassan, Mohd Izwan Zulaini Abdul Gani, Mohammad Azuwan Hassan and Azroei Denel

Stress response of tilapia, Oreochromis niloticus, when fed diets supplemented with sweet potato (I. Batatas) shoots and exposed to ammonia
Lander Cezar Plantado, Francis Nuestro Baleta, Patricia Magistrado-Candelaria, Diomerl Edward Bondad Baldo, Love Joy Pallaya-Baleta and Mylene Concina Navarro

Streptomyces flaveus as a potential biocontrol agent due to its ability to degrade fungal biomass and colloidal chitin
Phan Thi Huyen, Huynh Hong Quang and Lam Thi Hoa
Valorizing fish processing waste: Production of protein hydrolysates from milkfish (Chanos chanos) by-products using acid hydrolysis
Katherine DA. Bautista, Cesar V. Ortinero, Cyril Joy V. Balais, Danila S. Paragas, Sharon E. Lazaro, Redel L. Gutierrez and Rosalie R. Rafael

Groundwater recharge in Mekong River Delta: An application of the water-table fluctuation method in the Long Xuyen Quadrangle and the Ca Mau Peninsula
Le Thi Thuy Van, Rungruang Lertsirivorakul, Bui Tran Vuong and Chau Hong Thang

Similarity measure between Pythagorean fuzzy sets based on lower, upper and middle fuzzy sets with applications to pattern recognition and multicriteria decision making with PF-TODIM
Zahid Hussain, Farida Khanum, Shams Ur Rahman and Rashid Hussain
Analysis of the Ebola with a fractional-order model involving the Caputo-Fabrizio derivative
Nita H Shah and Kapil Chaudhary

Flow of a Casson fluid with heat transfer over a shrinking sheet and its dual solutions
Debasish Dey and Rupjyoti Borah

Asymptotic approximation of the norms of monomials in weighted Segal-Bargmann spaces
Phraewmai Wannateeradet and Kamthorn Chailuek

Effect of cadaverine on Brassica juncea (RH-30) seedlings under multiple stress - A quantitative analysis
Pushpa C. Tomar and Komal Arora

The effect of sulfur ratio to 2-2'-dithiobenzothiazole accelerator on viscoelastic, vibration damping, and thermal stability properties of gum natural rubber vulcanizates
Adi Cifriadi, Purwantiningsih Sugita, Tetty Kemala and Siti Nikmatin

Morphometric analysis and hydrological inferences for water resource management in Warana River basin of Maharashtra, India, using remote sensing and GIS
Suraj Kalgonda Patil and Tejaswini Nikhil Bhagwat

Groundwater potential mapping using GIS and remote sensing with multi-criteria decision-making in Shinile sub-basin, eastern Ethiopia
Tesema Kebede Seifu, Tenalem Ayenew, Taye Alemayehu and Tekalegn Ayele Woldesenbet

High dietary consumption of iodine induced thyroid cytotoxicity in diabetic intoxicated rats and oxidonitrergic stress in non-diabetic rats
Queen Eiza Bisi Ozegbe, Oyovwi Mega Obukohwo, Gideon Nimedia Aitokhuehi, Adesoji Adedipe Fasanmade, Lawrence Dayo Adedayo and Onome Bright Oghenetega

The efficacy of sodium benzoate and potassium sorbate in inhibiting the growth of food fungi and bacteria
Nurul Fatin Amilia Romli, Rashidah Sukor, Yaya Rukayadi and Aliah Zannierah Mohsin
Optimum levels of crude protein and metabolizable energy in diet as well as sexual effect on performance and carcass of Thai Native Crossbred Chicken (Pradu Hang Dam x Hubbard JA 57 Ki) during 1–13 weeks of age
Vanhnasouk Sayyadad, Boonlom Cheva-Isarakul and Suchon Tangtaweewipat








